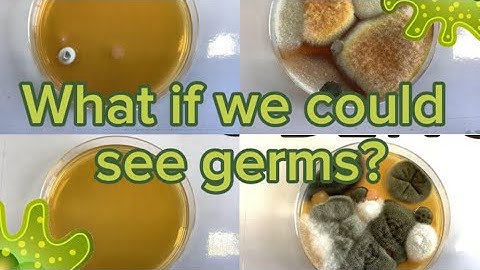

⬇ DOWNLOAD NOW
Kalau muncul iklan pop-up, tutup lalu klik tombol kembali
Download lagu What if you could see germs? secara gratis hanya untuk keperluan promosi. Dukung artis favorit kamu dengan membeli musik original di iTunes atau platform resmi lainnya.
 How To See Germs Spread Experiment (Coronavirus)
How To See Germs Spread Experiment (Coronavirus)
 The Invisible Challenge II – Spread of bacteria in hospital settings
The Invisible Challenge II – Spread of bacteria in hospital settings
What if we could see germs? 🦠 Reellife Science 🧬
What if we could see germs? 🦠 Reellife Science 🧬
 Must see bacteria what if you could see bacteria
Must see bacteria what if you could see bacteria
 Germs for kids | What are Germs? | How do germs spread? | How do we see germs?
Germs for kids | What are Germs? | How do germs spread? | How do we see germs?
 What Are Germs - How to Explain Germs and Bacteria to Kids - Wellness 101 Junior
What Are Germs - How to Explain Germs and Bacteria to Kids - Wellness 101 Junior
 Ultimate Sneaker Cleaning Steam Disinfect Sanitize Odor Germ Free Deodorize Remove Bacteria Method
Ultimate Sneaker Cleaning Steam Disinfect Sanitize Odor Germ Free Deodorize Remove Bacteria Method
 What If You Could See The Germs On Your Hands?
What If You Could See The Germs On Your Hands?